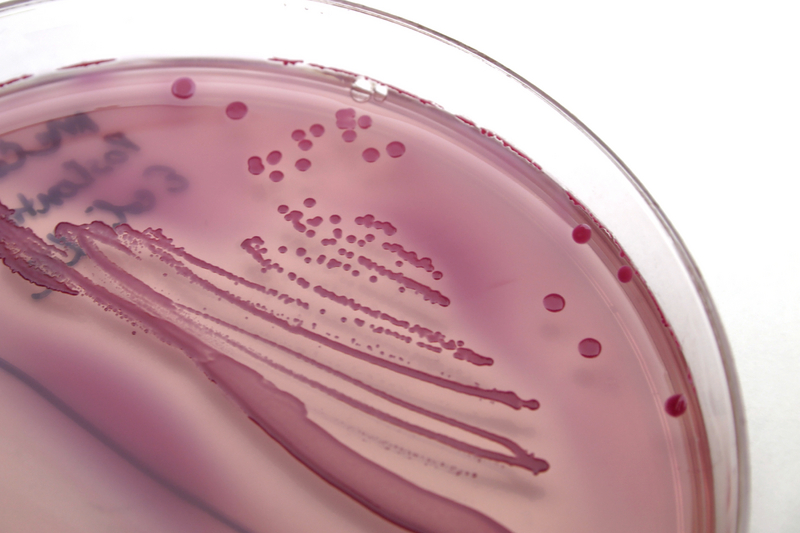

NZYStar
 Brand : NZYTech
Catalog No : MB005
Brand : NZYTech
Catalog No : MB005
Description: NZYStar Competent Cells are suitable for the general cloning protocols and for the construction of gene banks or the generation of cDNA libraries using plasmid-derived vectors. Tetracycline ensures that the selectable F' containing lac Z Δ M15 is maintained and thus eliminates the background of non-recombinant white colonies which have lost the F'. NZYStar Competent Cells are laqlq and require IPTG to induce expression from the lac promoter.
Genotype: endA1 hsdR17(rk-, mk+) supE44 thi -1 recA1 gyrA96 relA1 lac[F'proA+B+laclqZΔM15 :Tn10(TcR)]
Shipping and Storage: The NZYStar Chemically Competent Escherichia colicells are shipped on dry ice. Upon receipt, store at -80 °C.
System Components: NZYStar Competent Cells (10 or 20 × 200 µL)
Competent Cells Control Plasmid (10 µL at 0.1 ng/µL)
Quality Control: NZYStar Competent Cells consistently yield > 1.0 × 109 colony-forming units/µg competent cells control plasmid when transformed with non-saturating amounts of DNA (0.01 ng/100 µL cells).